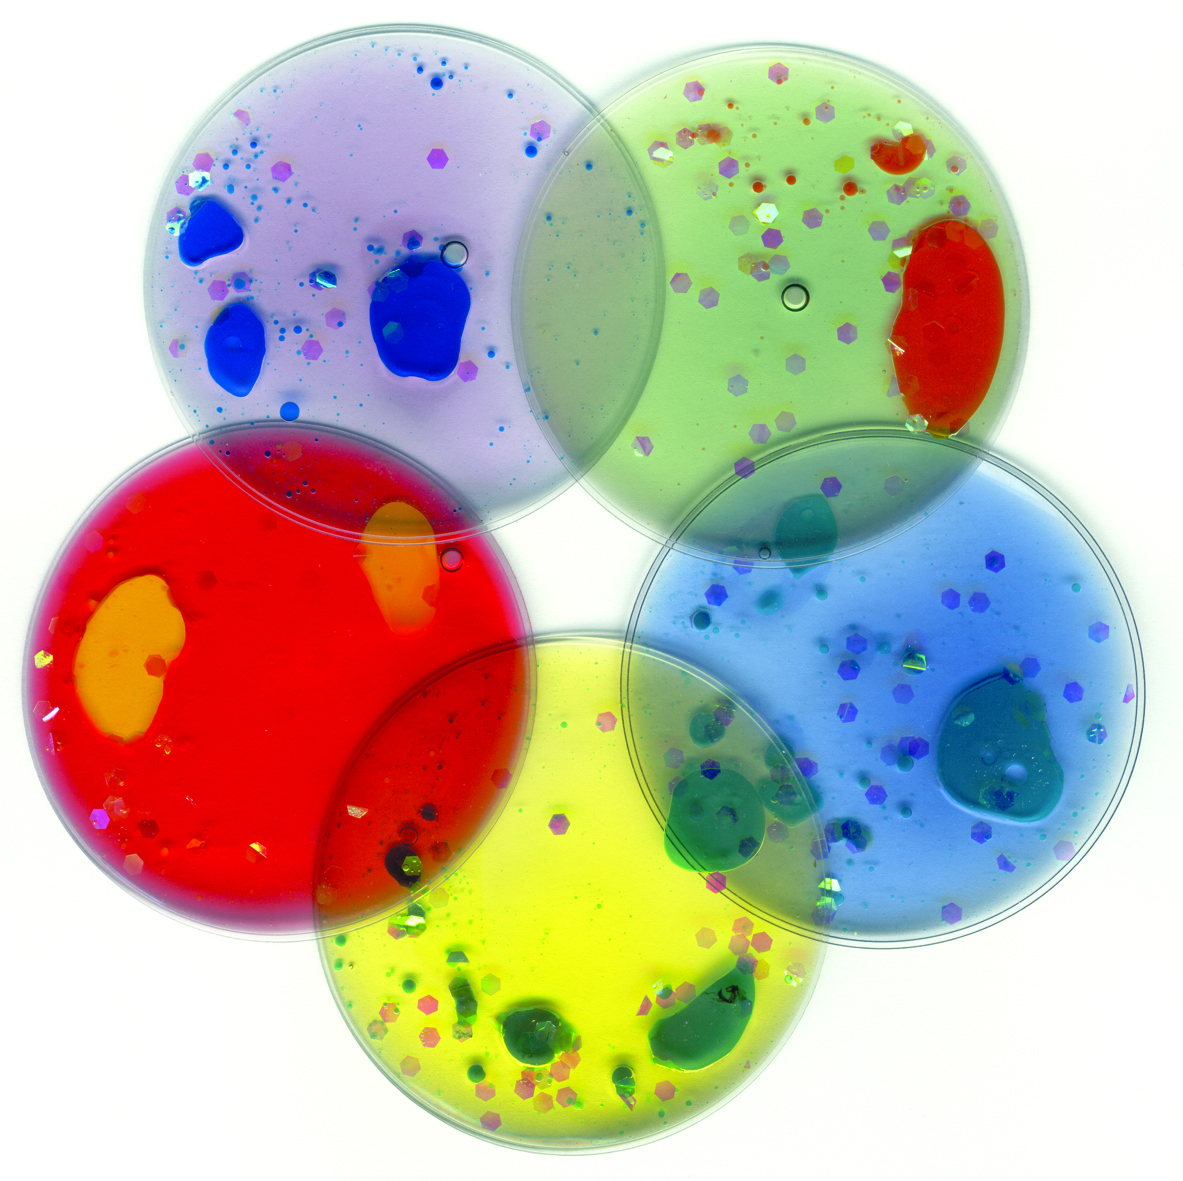
Glitzernde Gel Kissen klein 5er Set

Produktinformationen "Wassermatte"
Im Wasser schwimmende Sterne, Ringe und der Mond bewegen sich, wenn das Baby die Matte berührt. Ein Clown-Gesicht mit roter Nase lacht dem Baby entgegen. So macht Spielen auf dem Bauch richtig Spaß. Außerdem regt es Babys zum Zuschauen und Berühren an, während sie gleichzeitig ihre Grobmotorik entwickeln. Die Matte kann leicht befüllt werden.